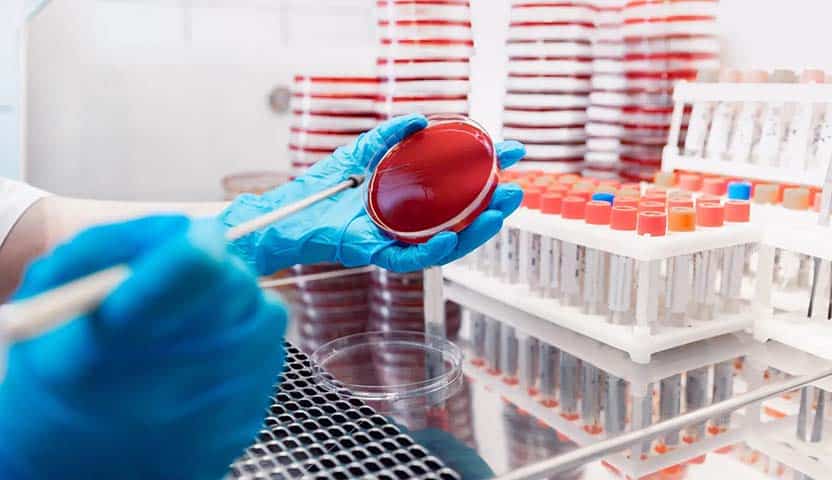

قد يتشابه مرض سرطان الدم والتهاب الدم في العديد من النقاط، وهذا ما يدفع بعض المرضى للاعتقاد أن كلا المرضين هما شيء واحد، وفي هذا المقال سنجيب على سؤال هام، وهو “هل التهاب الدم هو سرطان الدم؟” وسنتعرف أيضًا على العديد من المعلومات الدقيقة الخاصة بكلاً منهما.
هل التهاب الدم هو سرطان الدم؟
من الأسئلة الشائعة عن سرطان والتهاب الدم هو هل التهاب الدم هو سرطان الدم؟ والجواب عليها هو لا، ويختلف مرض التهاب الدم عن سرطان الدم كليًا، فهما مختلفان في الأسباب والأعراض وطرق علاج كل منهما، ومن الفروقات الجذرية التي تفصل بين سرطان الدم والتهاب الدم ما يلي:
- طريقة ظهور كل منهما: يظهر التهاب الدم عندما تصل بكتيريا ما إلى الدم، نتيجة وجود التهاب في مكان آخر من الجسم، مثل الرئة أو المسالك البولية، بصفة عامة يحدث المرض بسبب وجود بكتيريا في الدم، والتي تعمل على إفراز سموها في مختلف أنحاء الجسم، أما سرطان الدم فهو يحدث نتيجة نمو غير طبيعي في إحدى خلايا الدم، والتي غالبًا ما تتكون في نخاع العظم.
- نوع العلاج المستخدم: يختلف نوع العلاج المستخدم في كلا الحالتين، ففي التهاب الدم تستخدم المضادات الحيوية المناسبة للعلاج، أما في سرطان الدم، فيتم اللجوء إلى العلاج الكيماوي أو الإشعاعي طبقًا للحالة المرضية للمريض، وباقي الفروقات سوف يتم سردها خلال المقال.

الفرق بين التهاب الدم وسرطان الدم
بعد الإجابة على سؤال هل التهاب الدم هو سرطان الدم، وبعد أن تعرفنا أن هناك العديد من الفروقات بينهما، تتضمن هذه الفروقات التعريف أو المفهوم العام للمرض وهما كالتالي:
- التهاب الدم هو رد فعل الجسم تجاه الإصابة بعدوى في أحد أعضاء الجسم الحيوية، وهذه العدوى تنقل من العضو إلى الدم، مما يتسبب في ظهور التهاب الدم، وعادة ما تكون هذه العدوى بكتيرية، ويمكن أن تكون في فيروسية أو فطرية، وفي هذه الحالة، يفرز الجسم مواد كيميائية في الدم كرد فعل لوجود العدوى، هذه المواد تتسبب في هبوط شديد في ضغط الدم، مما يؤثر على كمية الدم التي تصل إلى الأعضاء الرئيسية، مثل الكبد والكلى والدماغ.
- سرطان الدم هو أحد أنواع السرطانات التي تؤثر على الدم، يبدأ هذا النوع من السرطان في نخاع العظم، الذي يساهم في خلق خلايا دم حمراء وخلايا دم بيضاء وصفائح دموية، وفي حال حدوث سرطان الدم، تحارب خلايا الدم الطبيعية العدوى، وتحمل الأكسجين إلى جميع أنحاء الجسم. ويحدث سرطان الدم عندما يتعطل تكوين الجسم لخلايا الدم.
تعرف أكثر على كيماوي سرطان الدم
الفرق بين أعراض التهاب وسرطان الدم
بعد أن تعرفنا على إجابة سؤال هل التهاب الدم هو نفسه سرطان الدم، دعونا نتعرف على الفرق في الأعراض بين كل منها، وهو كالتالي:
اعراض التهاب الدم
الإصابة بالتهاب الدم يظهر معه الكثير من الأعراض التي ينبغي الانتباه إليها، والتوجه إلى الطبيب المختص أو المراكز المتخصصة في حال ظهورها، والتي منها ما يلي:
- طفح جلدي يظهر في صورة بقع صغيرة حمراء داكنة على الجلد.
- مشاكل في المسالك البولية، مثل قلة التبول أو الرغبة في التبول.
- الشعور بضعف عام.
- زيادة معدل ضربات القلب.
- انخفاض ضغط الدم.
- الإصابة بالحمى.
- الشعور بألم شديد وعدم راحة.
- ضيق في التنفس.
أعراض سرطان الدم
تختلف أعراض سرطان الدم عن التهاب الدم، وأعراض سرطان الدم تختلف باختلاف نوع سرطان الدم، ومن الأعراض الشائعة التي تشير إلى الإصابة بسرطان الدم ما يلي:
- الشعور بالتعب والاعياء.
- التعرق الليلي الغزير.
- الإصابة بالحمى.
- فقدان الوزن غير المبرر.
- ظهور كدمات في الجسم.
- نزيف.
- حدوث التهابات متكررة.
- ألم في المفاصل والعظام.
- تورم العقد الليمفاوية.
- تضخم الكبد أو الطحال.
أسباب الإصابة بالتهاب الدم وسرطان الدم
من الأسئلة الشائعة في هذا المقال والتي تعرفنا عليها هل التهاب الدم هو سرطان الدم؟ دعونا نتعرف الآن على أسباب الإصابة بكل منهما وهما كالتالي:
أسباب الإصابة بالتهاب الدم
الالتهابات البكتيرية هي أحد الأسباب الأكثر شيوعًا للإصابة بالتهاب الدم، ويمكن أن تنتشر العدوى إلى أجزاء مختلفة في الجسم، وتشمل أنواع العدوى الشائعة التي تؤدي إلى التهاب الدم ما يلي:
- الإصابة ببعض أمراض الجهاز التنفسي.
- الالتهابات التي تصيب الرئتين.
- التهابات المسالك البولية.
- عدوى الزائدة الدودية.
- التهاب المرارة أو الكبد.
- التهابات في الدماغ أو الحبل الشوكي.
أسباب الإصابة بسرطان الدم
يحدث سرطان الدم عندما يحدث تغير أو تحور في الحمض النووي لخلايا الدم، وعندما يعطي الحمض النووي تعليمات جديدة للخلايا، يبدأ الجسم على الفور بتكوين خلايا دم غير طبيعية، تنمو هذه الخلايا وتتكاثر بشكل أسرع من الطبيعي، بالتالي تزاحم خلايا الدم الطبيعية، وتحتكر المساحة في نخاع العظم، مما يدفع نخاع العظم لإنتاج عدد أقل من الخلايا الطبيعية، مما يعني أنه لا توجد خلايا طبيعية كافية للقيام بالمهام الأساسية وهي حمل الأكسجين، ومكافحة العدوى والسيطرة على النزيف.
كيف يتم تشخيص التهاب الدم؟
توجد بعض الفروقات في تشخيص كلا من التهاب الدم وسرطان الدم، دعونا نتعرف عليها بعد أن تعرفنا على إجابة سؤال هل التهاب الدم هو سرطان الدم، من أهم طرق التشخيص المستخدمة في حالة التهاب الدم ما يلي:
- اختبارات الدم: التي تتضمن تعداد الدم الكامل (CBC).
- الفحص البدني.
- الاختبارات المعملية منها اختبارات البول.
- الأشعة السينية أو الأشعة المقطعية.
- مستوى الأكسجين في الدم.
تعرف المزيد عن هل سرطان الدم معدي؟
كيف يتم تشخيص سرطان الدم؟
توجد العديد من الاختبارات والفحوصات التي يطلبها الطبيب للتأكد من التشخيص في حالة الإصابة بسرطان الدم، وتشمل هذه الاختبارات ما يلي:
- تعداد الدم الكامل (CBC).
- اختبار كيمياء الدم.
- التصوير المقطعي المحوسب (CT).
- التصوير بالرنين المغناطيسي (MRI).
- فحص خلايا الدم.
الفرق بين علاج سرطان الدم والتهاب الدم
توجد العديد من الفروقات في طرق العلاج المتبعة مع سرطان الدم والتهاب الدم، دعونا نتعرف عليها بعد أن أجبنا على سؤال هل التهاب الدم هو سرطان الدم، تتمثل هذه الفروقات فيما يلي:
علاج التهاب الدم
كلما كان تشخيص الإصابة بالتهاب الدم مبكر، كلما أعطى العلاج نتائجه بسرعة، لذا في حالة التهاب الدم، يجب البدء باستخدام العلاج فور التشخيص، وتوجد بعض الخيارات المتاحة للعلاج، والتي يختار منها الطبيب المناسب حسب الحالة الصحية للمريض، وهذه الخيارت تتمثل في الآتي:
- المضادات الحيوية: غالبًا ما يوصي بها الطبيب إذا كان المريض يعاني من عدوى بكتيرية.
- السوائل الوريدية: وهي من الخيارات العلاجية التي يوصي بها الطبيب للحفاظ على تدفق الدم ومنع انخفاض ضغط الدم.
- الأدوية القابضة للأوعية الدموية: يوصي الطبيب باستخدامها من أجل الحصول على ضغط دم طبيعي ومستقر.
- علاجات أخرى: يمكن أن يحتاج المريض إلى بعض الإجراءات الأخرى، مثل الغسيل الكلوي في حالة الفشل الكلوي أو التهوية الميكانيكية في حالة فشل الجهاز التنفسي.
- الجراحة: يمكن أن يوصي الطبيب بإجراء عملية جراحية للتخلص من الأنسجة التالفة.
علاج سرطان الدم
بعد أن أجبنا على سؤال هل التهاب الدم هو سرطان الدم، دعونا نتعرف على طريقة علاج هذا المرض، بالنسبة لمرض سرطان الدم، توجد العديد من طرق العلاج المتبعة، والتي يوصي الطبيب بإحداها بناءًا على عمر وصحته المريض العامة ونوع سرطان الدم الذي يعاني منه، :وتشمل هذه الخيارات ما يلي
- العلاج الكيميائي: هو العلاج الألي لسرطان الدم، يعمل هذا العلاج على قتل الخلايا السرطانية لإبطاء تقدم المرض.
- العلاج الإشعاعي: يمكن أن يستخدم الأطباء العلاج الإشعاعي في علاج سرطان الدم، ويستهدف العلاج الإشعاعي الخلايا غير الطبيعية، مما يؤدي إلى تلف الحمض النووي الخاص بها، بالتالي يصعب أن تتكاثر هذه الخلايا.
- العلاج المناعي: يساعد العلاج الجهاز المناعي في جسم المريض على إنتاج المزيد من الخلايا المناعية، كما يساعد الخلايا المناعية الموجودة لدى المريض في العثور على الخلايا السرطانية وقتلها.
- العلاج الموجه للسرطان: يستهدف علاج السرطان هذا التغيرات الجينية التي تتسبب في تحول الخلايا السليمة إلى خلايا غير طبيعية.
في الختام، بعد أن تعرفنا على الجواب التفصيلي لسؤال هل التهاب الدم هو سرطان الدم؟ وبعد أن عرفنا أنه توجد العديد من الفروقات بينهما، بالتالي من غير الممكن أن يكون التهاب الدم هو سرطان الدم، ولكن لكل منهما طرق العلاج المناسبة التي يمكن استخدامها من أجل الشفاء من المرض، ينبغي التوجه على الفور إلى أفضل مركز متخصص في علاج مشكلة سرطان الدم، وهو مركز أمراض الدم والأورام.
تعرف المزيد عن هل تكسر الدم سرطان؟




